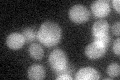
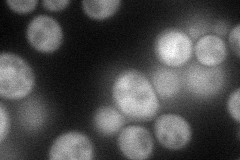
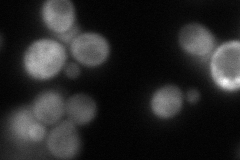
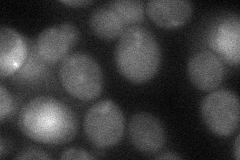
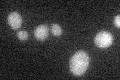

View description
Putative protein of unknown function; phosphorylated by Dbf2p-Mob1p in vitro; some strains contain microsatellite polymophisms at this locus; YLR177W is not an essential gene
Localization:
Intensity:
Fold change:
Significance:
-
C’ GFP library in SD
cytosol22.11 -
N' NOP1pr-GFP in SD
cytosol57.783 -
N' TEF2pr-mCherry in SD
cytosol7.25927 -
N' NATIVEpr-GFP in SD

cytosol20.6698 -
N' TEF2pr-VC and Cyto-VN in SD
cytosol39.3067 -
C’ GFP library in SD+DTT

cytosol28.511.28No -
C’ GFP library in SD+H2O2

cytosol29.411.33Yes -
C’ GFP library in Starvation Media
cytosol33.891.53No -
C’ GFP library on the background of Pup2-DaMP

cytosol -
C’ GFP library on the background of CCT mutant

cytosol25.82371.16778No
